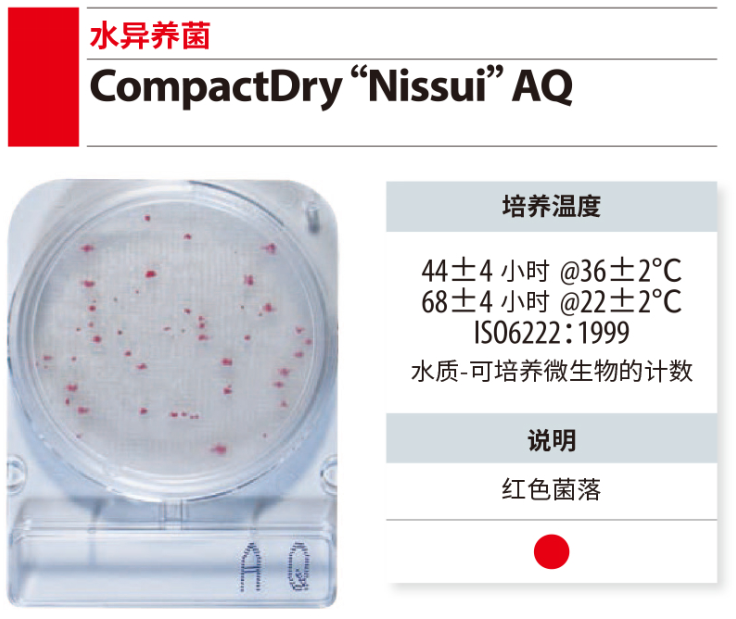
CompactDry 微生物快速测试片-2

岛津|shimadzu|RubyPro, Protein Crash 96-well plate, 1ml, 1/pkg|货号 OMNPPT20-1|生物样品前处理|蛋白沉淀板,96孔板, 1ml,1个装
岛津|shimadzu|RubyPro, Protein Crash 96-well plate, 1ml, 1/pkg|货号 OMNPPT20-1|生物样品前处理|蛋白沉淀板,96孔板, 1ml,1个装
 岛津|shimadzu|RubyPro, Protein Crash 96-well plate, 1mL, 10/pkg|货号 OMNPPT20-10|生物样品前处理|蛋白沉淀板,96孔板, 1ml,10个装
岛津|shimadzu|RubyPro, Protein Crash 96-well plate, 1mL, 10/pkg|货号 OMNPPT20-10|生物样品前处理|蛋白沉淀板,96孔板, 1ml,10个装
 岛津|shimadzu|RubyPro, Protein Crash 96-well plate, 0.4mL, 1/pkg|货号 OC04PPT20|生物样品前处理|蛋白沉淀板,96孔板, 0.4ml,1个装
岛津|shimadzu|RubyPro, Protein Crash 96-well plate, 0.4mL, 1/pkg|货号 OC04PPT20|生物样品前处理|蛋白沉淀板,96孔板, 0.4ml,1个装
 岛津|shimadzu|RubyPro, Protein Crash 96-well plate, 2mL, 1/pkg|货号 OC21PPT20-1|生物样品前处理|蛋白沉淀板,96孔板, 2ml,1个装
岛津|shimadzu|RubyPro, Protein Crash 96-well plate, 2mL, 1/pkg|货号 OC21PPT20-1|生物样品前处理|蛋白沉淀板,96孔板, 2ml,1个装
 岛津|shimadzu|MatriKleen plate, 2mL/well, 1/pkg|货号 OC21MKS50R|生物样品前处理|蛋白磷脂去除板,96孔板, 2ml
岛津|shimadzu|MatriKleen plate, 2mL/well, 1/pkg|货号 OC21MKS50R|生物样品前处理|蛋白磷脂去除板,96孔板, 2ml

报价:面议
已咨询1次生物耗材

报价:面议
已咨询0次生物耗材

报价:面议
已咨询0次生物耗材

报价:面议
已咨询0次生物耗材

报价:面议
已咨询0次生物耗材

报价:面议
已咨询1次生物耗材

报价:面议
已咨询2次生物耗材

报价:面议
已咨询2次生物耗材

货号:BNCC363487 规格:单管 单位:盒 浓度:(6.1±1.2)×10^6copies/mL

货号:BNCC394163 规格:10管/盒;500μL/管 单位:盒 浓度:10^4~10^5copies/mL

货号:BNCC394164 规格:10管/盒;500μL/管 单位:盒 浓度:10^5~10^6copies/mL

货号:BNCC394165 规格:10管/盒;500μL/管 单位:盒 浓度:10^7~10^8copies/mL

货号:BWZ7927-2016A 规格:2支/套 单位:套 浓度:4组分 适用标

货号:A50485 规格:1pk 单位:套 浓度:100 preps, Each

货号:4466351 规格:1pk 单位:套 浓度:52 次分离, Each 适

货号:4467754 规格:1pk 单位:套 浓度:1 instrument, Each